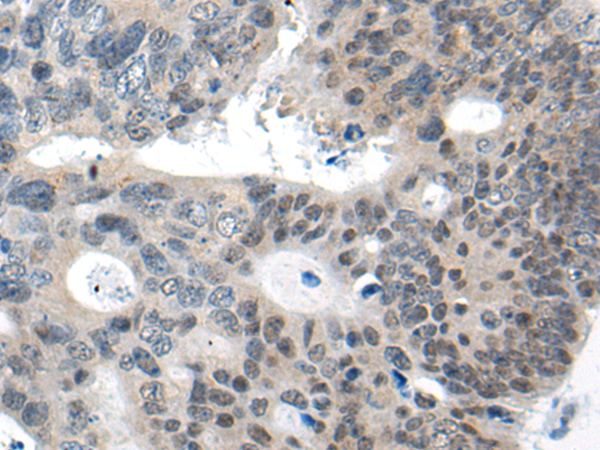

|
Background: |
CHURC1, also known as protein Churchill, is a 112 amino acid protein that plays a critical role in neural induction during embryogenesis. The fibroblast growth family of proteins (FGFs) has been identified as necessary factors in mesoderm formation and neural induction. CHURC1, a putative zinc finger protein, is a transcriptional activator that mediates FGF signaling. Furthermore, CHURC1 is thought to play a role in the regulation of cell movement. Although CHURC1 does not bind to DNA, it functions as a transcriptional regulator and a protein-interaction factor. Two isoforms of CHURC1 exist as a result of alternative splicing events. |
|
Applications: |
ELISA, IHC |
|
Name of antibody: |
CHURC1 |
|
Immunogen: |
Synthetic peptide of human CHURC1 |
|
Full name: |
churchill domain containing 1 |
|
Synonyms: |
chch; My015; C14orf52 |
|
SwissProt: |
Q8WUH1 |
|
ELISA Recommended dilution: |
5000-10000 |
|
IHC positive control: |
Human colorectal cancer |
|
IHC Recommend dilution: |
20-100 |
購物車
購物車 幫助
幫助
 021-54845833/15800441009
021-54845833/15800441009
